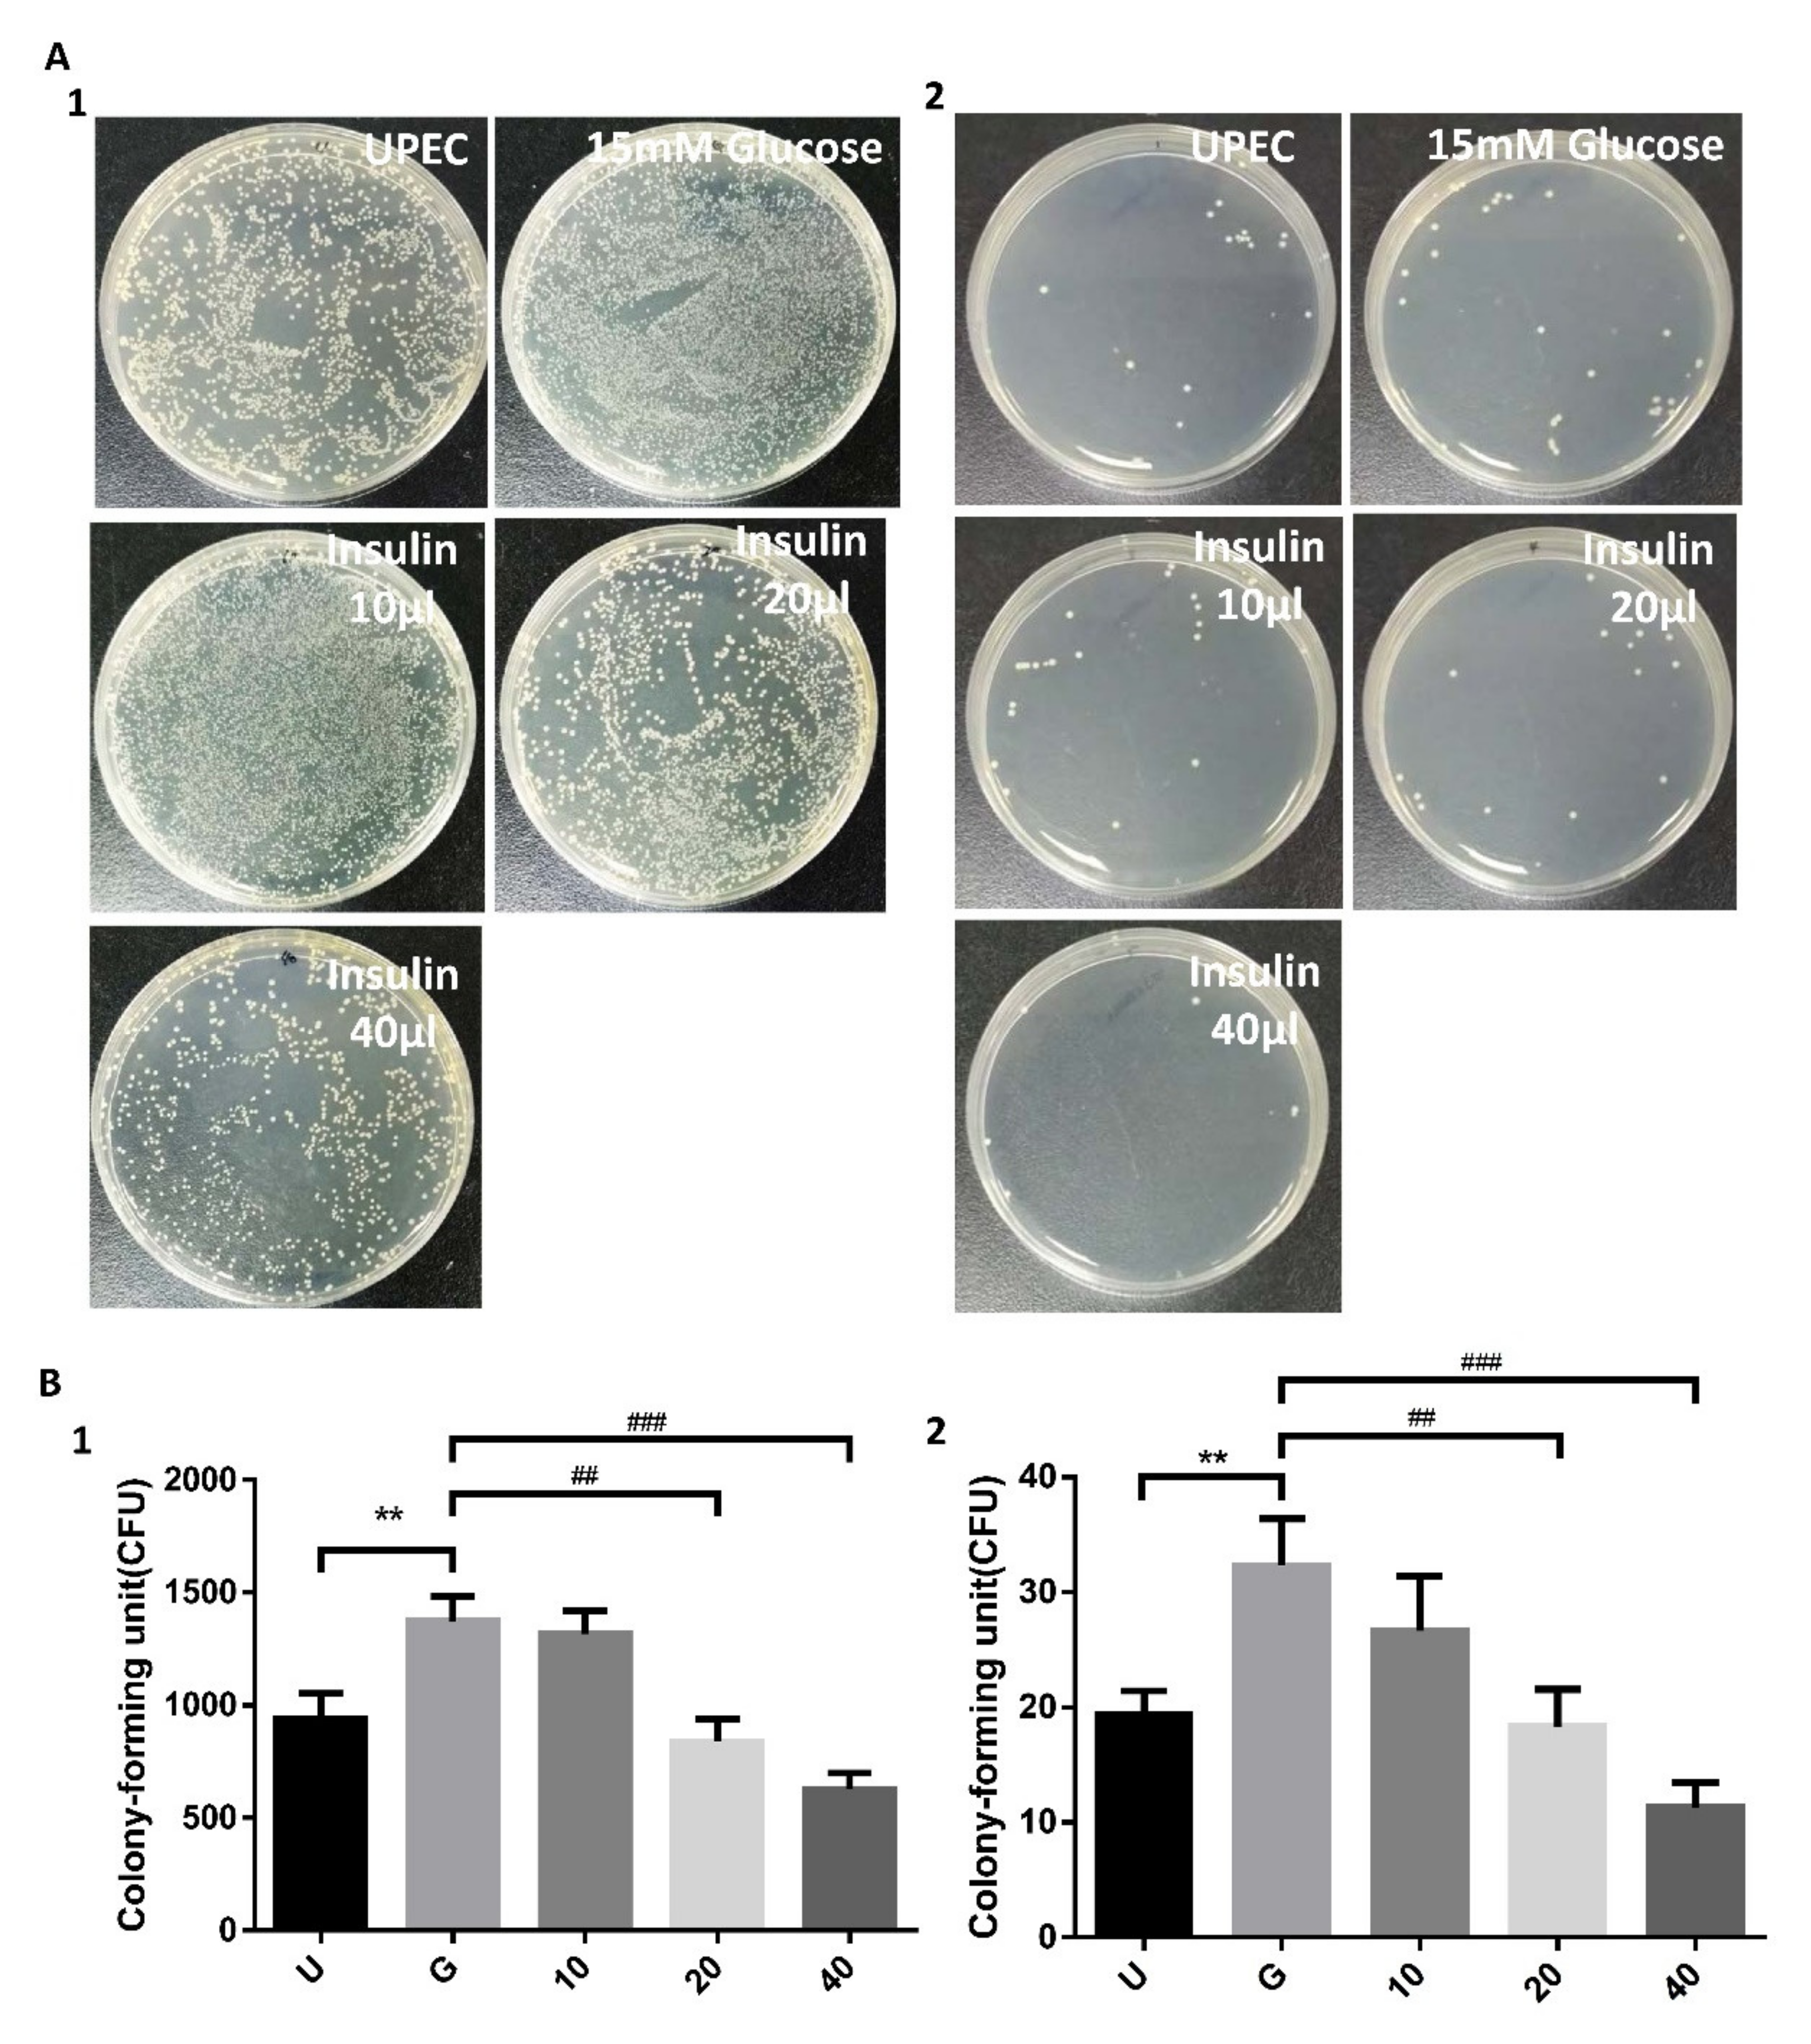
Microorganisms 09 02421 g001

Insulin Downregulated the Infection of Uropathogenic Escherichia coli (UPEC) in Bladder Cells in a High-Glucose Environment through JAK/STAT Signaling Pathway
Abstract
1. Introduction
2. Materials and Methods
2.1. Bacterial Strain
2.2. Bladder Cell Culture, Insulin Pre-Treatment and UPEC Infection
2.3. UPEC Infections and Quantifying
2.4. Cell Protein Extraction
2.5. Western Blotting
2.6. RNA Isolation and RT-PCR
2.7. Flow Cytometry
2.8. Statistical Analysis
3. Results
3.1. Insulin Dose-Dependently Reduces UPEC Infection in Bladder Cells in a High-Glucose Environment
3.2. Insulin Reduces UPEC Infection and Downregulates the Expression of STAT-1/3 and IR in SV-HUC-1 Cells
3.3. Insulin-Mediated Reduction of UPEC Infection in Bladder Cells Is Related to Downregulation of the JAK/STAT1 Signaling Pathway and TLR-4 Expression
4. Discussion
5. Conclusions
Supplementary Materials
Author Contributions
Funding
Conflicts of Interest
References
- Goldstein, I.; Dicks, B.; Kim, N.N.; Hartzell, R. Multidisciplinary Overview of Vaginal Atrophy and Associated Genitourinary Symptoms in Postmenopausal Women. Sex. Med. 2013, 1, 44–53. [Google Scholar] [CrossRef] [PubMed]
- Dielubanza, E.J.; Schaeffer, A.J. Urinary Tract Infections in Women. Med. Clin. 2011, 95, 27–41. [Google Scholar] [CrossRef] [PubMed]
- Lee, J.B.L.; Neild, G.H. Urinary Tract Infection. Medicine 2007, 35, 423–428. [Google Scholar] [CrossRef]
- Naber, K.G.; Schito, G.; Botto, H.; Palou, J.; Mazzei, T. Surveillance Study in Europe and Brazil on Clinical Aspects and Antimicrobial Resistance Epidemiology in Females with Cystitis (Aresc): Implications for Empiric Therapy. Eur. Urol. 2008, 54, 1164–1178. [Google Scholar] [CrossRef]
- Ronald, A. The Etiology of Urinary Tract Infection: Traditional and Emerging Pathogens. Dis. Mon. 2003, 49, 71–82. [Google Scholar] [CrossRef]
- Chung, A.; Arianayagam, M.; Rashid, P. Bacterial Cystitis in Women. Aust. Fam. Physician 2010, 39, 295. [Google Scholar]
- Geerlings, S.E. Urinary Tract Infections in Patients with Diabetes Mellitus: Epidemiology, Pathogenesis and Treatment. Int. J. Antimicrob. Agents 2008, 31, 54–57. [Google Scholar] [CrossRef]
- Wang, L.; Wang, J.; Fang, J.; Zhou, H.; Liu, X.; Su, S.B. High Glucose Induces and Activates Toll-Like Receptor 4 in Endothelial Cells of Diabetic Retinopathy. Diabetol. Metab. Syndr. 2015, 7, 1–10. [Google Scholar] [CrossRef]
- Kuo, C.-Y.; Lin, C.-Y.; Chen, T.-C.; Lin, W.-R.; Lu, P.-L.; Tsai, J.-J.; Chang, K.; Hsieh, H.-C.; Chen, Y.-H. Clinical Features and Prognostic Factors of Emphysematous Urinary Tract Infection. J. Microbiol. Immunol. Infect. Wei Mian Yu Gan Ran Za Zhi 2009, 42, 393–400. [Google Scholar]
- Valerius, N.; Eff, C.; Hansen, N.; Karle, H.; Nerup, J.; Søeberg, B.; Sørensen, S. Neutrophil and Lymphocyte Function in Patients with Diabetes Mellitus. Acta Med. Scand. 1982, 211, 463–467. [Google Scholar] [CrossRef] [PubMed]
- Geerlings, S.E.; Stolk, R.P.; Camps, M.; Netten, P.M.; Hoekstra, J.; Bouter, K.P.; Bravenboer, B.; Collet, J.T.; Jansz, A.R.; Hoepelman, A. Asymptomatic Bacteriuria May Be Considered a Complication in Women with Diabetes. Diabetes Mellitus Women Asymptomatic Bacteriuria Utrecht Study Group. Diabetes Care 2000, 23, 744–749. [Google Scholar] [CrossRef]
- Taganna, J.; de Boer, A.R.; Wuhrer, M.; Bouckaert, J. Glycosylation Changes as Important Factors for the Susceptibility to Urinary Tract Infection; Portland Press Ltd.: London, UK, 2011. [Google Scholar]
- Tseng, C.-C.; Wu, J.-J.; Wang, M.-C.; Hor, L.-I.; Ko, Y.-H.; Huang, J.-J. Host and Bacterial Virulence Factors Predisposing to Emphysematous Pyelonephritis. Am. J. Kidney Dis. 2005, 46, 432–439. [Google Scholar] [CrossRef] [PubMed]
- Devaraj, S.; Dasu, M.R.; Rockwood, J.; Winter, W.; Griffen, S.C.; Jialal, I. Increased Toll-Like Receptor (Tlr) 2 and Tlr4 Expression in Monocytes from Patients with Type 1 Diabetes: Further Evidence of a Proinflammatory State. J. Clin. Endocrinol. Metab. 2008, 93, 578–583. [Google Scholar] [CrossRef]
- O’Shea, J.J.; Plenge, R. Jak and Stat Signaling Molecules in Immunoregulation and Immune-Mediated Disease. Immunity 2012, 36, 542–550. [Google Scholar] [CrossRef] [PubMed]
- Mashili, F.; Chibalin, A.V.; Krook, A.; Zierath, J.R. Constitutive Stat3 Phosphorylation Contributes to Skeletal Muscle Insulin Resistance in Type 2 Diabetes. Diabetes 2013, 62, 457–465. [Google Scholar] [CrossRef] [PubMed]
- Kim, T.H.; Choi, S.E.; Ha, E.S.; Jung, J.G.; Han, S.J.; Kim, H.J.; Kim, D.J.; Kang, Y.; Lee, K.W. Il-6 Induction of Tlr-4 Gene Expression Via Stat3 Has an Effect on Insulin Resistance in Human Skeletal Muscle. Acta Diabetol. 2013, 50, 189–200. [Google Scholar] [CrossRef]
- Jiang, L.Q.; Duque-Guimaraes, D.E.; Machado, U.F.; Zierath, J.R.; Krook, A. Altered Response of Skeletal Muscle to Il-6 in Type 2 Diabetic Patients. Diabetes 2013, 62, 355–361. [Google Scholar] [CrossRef] [PubMed]
- White, A.T.; LaBarge, S.A.; McCurdy, C.E.; Schenk, S. Knockout of Stat3 in Skeletal Muscle Does Not Prevent High-Fat Diet-Induced Insulin Resistance. Mol. Metab. 2015, 4, 569–575. [Google Scholar] [CrossRef]
- Taniguchi, C.M.; Emanuelli, B.; Kahn, C.R. Critical Nodes in Signalling Pathways: Insights into Insulin Action. Nat. Rev. Mol. Cell Biol. 2006, 7, 85–96. [Google Scholar] [CrossRef]
- Murtha, M.J.; Eichler, T.; Bender, K.; Metheny, J.; Li, B.; Schwaderer, A.L.; Mosquera, C.; James, C.; Schwartz, L.; Becknell, B.; et al. Insulin Receptor Signaling Regulates Renal Collecting Duct and Intercalated Cell Antibacterial Defenses. J. Clin. Investig. 2018, 128, 5634–5646. [Google Scholar] [CrossRef]
- Hale, L.J.; Coward, R.J. Insulin Signalling to the Kidney in Health and Disease. Clin. Sci. 2013, 124, 351–370. [Google Scholar] [CrossRef] [PubMed]
- Ho, C.H.; Fan, C.K.; Wu, C.C.; Yu, H.J.; Liu, H.T.; Chen, K.C.; Liu, S.P.; Cheng, P.C. Enhanced Uropathogenic Escherichia Coli-Induced Infection in Uroepithelial Cells by Sugar through Tlr-4 and Jak/Stat1 Signaling Pathways. J. Microbiol. Immunol. Infect. 2021, 54, 193–205. [Google Scholar] [CrossRef] [PubMed]
- Ho, C.H.; Fan, C.K.; Wu, C.C.; Yu, H.J.; Liu, H.T.; Chen, K.C.; Liu, S.P.; Cheng, P.C. Testosterone Suppresses Uropathogenic Escherichia Coli Invasion and Colonization within Prostate Cells and Inhibits Inflammatory Responses through Jak/Stat-1 Signaling Pathway. PLoS ONE 2017, 12, e0180244. [Google Scholar]
- Berry, R.E.; Klumpp, D.J.; Schaeffer, A.J. Urothelial Cultures Support Intracellular Bacterial Community Formation by Uropathogenic Escherichia Coli. Infect. Immun. 2009, 77, 2762–2772. [Google Scholar] [CrossRef]
- Eichler, T.E.; Becknell, B.; Easterling, R.S.; Ingraham, S.E.; Cohen, D.M.; Schwaderer, A.L.; Hains, D.S.; Li, B.; Cohen, A.; Metheny, J.; et al. Insulin and the Phosphatidylinositol 3-Kinase Signaling Pathway Regulate Ribonuclease 7 Expression in the Human Urinary Tract. Kidney Int. 2016, 90, 568–579. [Google Scholar] [CrossRef]
- Ho, C.H.; Lu, Y.C.; Fan, C.K.; Yu, H.J.; Liu, H.T.; Wu, C.C.; Chen, K.C.; Liu, S.P.; Cheng, P.C. Testosterone Regulates the Intracellular Bacterial Community Formation of Uropathogenic Escherichia Coli in Prostate Cells Via Stat3. Int. J. Med. Microbiol. 2020, 310, 151450. [Google Scholar] [CrossRef]
- Haeusler, R.A.; McGraw, T.E.; Accili, D. Biochemical and Cellular Properties of Insulin Receptor Signalling. Nat. Rev. Mol. Cell Biol. 2018, 19, 31–44. [Google Scholar] [CrossRef] [PubMed]
- Van Niekerk, G.; Dalgleish, A.G.; Joubert, F.; Joubert, A.; Engelbrecht, A.M. The Immuno-Oncological Implications of Insulin. Life Sci. 2021, 264, 118716. [Google Scholar] [CrossRef]
- Nohr, M.K.; Dudele, A.; Poulsen, M.M.; Ebbesen, L.H.; Radko, Y.; Christensen, L.P.; Jessen, N.; Richelsen, B.; Lund, S.; Pedersen, S.B. Lps-Enhanced Glucose-Stimulated Insulin Secretion Is Normalized by Resveratrol. PLoS ONE 2016, 11, e0146840. [Google Scholar] [CrossRef]
- Kellerer, M.; Koch, M.; Metzinger, E.; Mushack, J.; Capp, E.; Haring, H.U. Leptin Activates Pi-3 Kinase in C2c12 Myotubes Via Janus Kinase-2 (Jak-2) and Insulin Receptor Substrate-2 (Irs-2) Dependent Pathways. Diabetologia 1997, 40, 1358–1362. [Google Scholar] [CrossRef][Green Version]
- Ferretti, E.; Corcione, A.; Pistoia, V. The IL-31/IL-31 receptor axis: General features and role in tumor microenvironment. J. Leukoc. Biol. 2017, 102, 711–717. [Google Scholar] [CrossRef] [PubMed]
- Demirel, I.; Save, S.; Kruse, R.; Persson, K. Expression of Suppressor of Cytokine Signalling 3 (Socs3) in Human Bladder Epithelial Cells Infected with Uropathogenic Escherichia Coli. Apmis 2013, 121, 158–167. [Google Scholar] [CrossRef]
- Yoshimura, A.; Naka, T.; Kubo, M. Socs Proteins, Cytokine Signalling and Immune Regulation. Nat. Rev. Immunol. 2007, 7, 454–465. [Google Scholar] [CrossRef]
- Croker, B.A.; Krebs, D.L.; Zhang, J.G.; Wormald, S.; Willson, T.A.; Stanley, E.G.; Robb, L.; Greenhalgh, C.J.; Forster, I.; Clausen, B.E.; et al. Socs3 Negatively Regulates Il-6 Signaling in Vivo. Nat. Immunol. 2003, 4, 540–545. [Google Scholar] [CrossRef]
- Wood, M.W.; Breitschwerdt, E.B.; Gookin, J.L. Autocrine Effects of Interleukin-6 Mediate Acute-Phase Proinflammatory and Tissue-Reparative Transcriptional Responses of Canine Bladder Mucosa. Infect. Immun. 2011, 79, 708–715. [Google Scholar] [CrossRef] [PubMed]
- Minokoshi, Y.; Kahn, C.R.; Kahn, B.B. Tissue-Specific Ablation of the Glut4 Glucose Transporter or the Insulin Receptor Challenges Assumptions About Insulin Action and Glucose Homeostasis. J. Biol. Chem. 2003, 278, 33609–33612. [Google Scholar] [CrossRef]
- Gumus, D.; Yoruk, E.; Kalayci-Yuksek, F.; Uz, G.; Topal-Sarikaya, A.; Ang-Kucuker, M. The Effects of Insulin and Glucose on Different Characteristics of a Upec: Alterations in Growth Rate and Expression Levels of Some Virulence Genes. Clin. Lab. 2017, 63, 1589–1597. [Google Scholar] [CrossRef]
- Madani, A.Y.; Majeed, Y.; Abdesselem, H.B.; Agha, M.V.; Vakayil, M.; Sukhun, N.K.A.; Halabi, N.M.; Kumar, P.; Hayat, S.; Elrayess, M.A.; et al. Signal Transducer and Activator of Transcription 3 (Stat3) Suppresses Stat1/Interferon Signaling Pathway and Inflammation in Senescent Preadipocytes. Antioxidants 2021, 10, 334. [Google Scholar] [CrossRef] [PubMed]

Publisher’s Note: MDPI stays neutral with regard to jurisdictional claims in published maps and institutional affiliations. |
© 2021 by the authors. Licensee MDPI, Basel, Switzerland. This article is an open access article distributed under the terms and conditions of the Creative Commons Attribution (CC BY) license (https://creativecommons.org/licenses/by/4.0/).
Share and Cite
Ho, C.-H.; Liu, S.-P.; Fan, C.-K.; Tzou, K.-Y.; Wu, C.-C.; Cheng, P.-C. Insulin Downregulated the Infection of Uropathogenic Escherichia coli (UPEC) in Bladder Cells in a High-Glucose Environment through JAK/STAT Signaling Pathway. Microorganisms 2021, 9, 2421. https://doi.org/10.3390/microorganisms9122421
Ho C-H, Liu S-P, Fan C-K, Tzou K-Y, Wu C-C, Cheng P-C. Insulin Downregulated the Infection of Uropathogenic Escherichia coli (UPEC) in Bladder Cells in a High-Glucose Environment through JAK/STAT Signaling Pathway. Microorganisms. 2021; 9(12):2421. https://doi.org/10.3390/microorganisms9122421
Chicago/Turabian StyleHo, Chen-Hsun, Shih-Ping Liu, Chia-Kwung Fan, Kai-Yi Tzou, Chia-Chang Wu, and Po-Ching Cheng. 2021. "Insulin Downregulated the Infection of Uropathogenic Escherichia coli (UPEC) in Bladder Cells in a High-Glucose Environment through JAK/STAT Signaling Pathway" Microorganisms 9, no. 12: 2421. https://doi.org/10.3390/microorganisms9122421
APA StyleHo, C.-H., Liu, S.-P., Fan, C.-K., Tzou, K.-Y., Wu, C.-C., & Cheng, P.-C. (2021). Insulin Downregulated the Infection of Uropathogenic Escherichia coli (UPEC) in Bladder Cells in a High-Glucose Environment through JAK/STAT Signaling Pathway. Microorganisms, 9(12), 2421. https://doi.org/10.3390/microorganisms9122421

